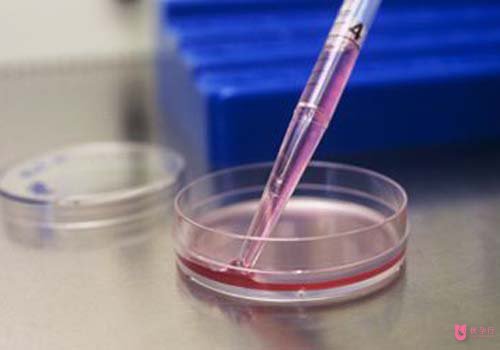
timg (3).jpg

當(dāng)前位置:美國(guó)試管嬰兒 > 美國(guó)試管嬰兒進(jìn)入周期后的注意事項(xiàng)有哪些
時(shí)間:2018-12-27
??試管嬰兒花費(fèi)不菲,雖然說(shuō)赴美試管嬰兒成功率高,但是影響試管嬰兒成功率的因素也很多,因此,在進(jìn)入試管嬰兒周期后,要注意的問(wèn)題也很多。

一、降調(diào)期間的注意事項(xiàng)
1、配合醫(yī)生治療非常關(guān)鍵,切記要遵醫(yī)囑。
2、飲食安排要合理。降調(diào)期間飲食要多元化,保持營(yíng)養(yǎng)均衡!多吃水果、高蛋白食物;切忌辛辣、活血類(lèi)食物,如紅棗、桂圓等!
3、要有適當(dāng)?shù)倪\(yùn)動(dòng)。特別是多囊卵巢綜合征的患者和肥胖的患者,更要注意適當(dāng)運(yùn)動(dòng),適當(dāng)運(yùn)動(dòng)有利于拿到優(yōu)質(zhì)的卵泡并能順利懷孕。
4、保持愉快的心情,不要過(guò)于緊張,過(guò)于緊張可咨詢心理醫(yī)師,調(diào)整好自己心態(tài)。
5、降調(diào)藥物放置于2-8攝氏度保存,來(lái)回醫(yī)院路上用冰塊和冷藏包攜帶,回家后放置冰箱冷藏室。降調(diào)針的第一針在醫(yī)院注射室注射,其他的降調(diào)針可以帶回家到附近診所或者醫(yī)院注射。
6、用藥過(guò)程中不能中斷,皮下注射。月經(jīng)期正常用藥。促排卵后也仍然繼續(xù)用藥。
7、按醫(yī)囑用藥,盡量上午打針。
8、降調(diào)期間如果出現(xiàn)疾病,都是可以正常用藥的,用藥時(shí)間盡量和降調(diào)針時(shí)間錯(cuò)開(kāi)幾個(gè)小時(shí)。
二、促排期間的注意事項(xiàng)
1、切忌熬夜,早睡早起!
2、保持愉快心情,穩(wěn)定情緒。不急不躁,心緒平靜!
3、不要提重物;不要喝含酒精的飲料;不要使用止痛或者鎮(zhèn)靜之類(lèi)的藥物。如促排期間出現(xiàn)發(fā)熱、咳嗽、腹瀉、皮疹及其他內(nèi)外科疾病,必須及時(shí)在綜合醫(yī)院相應(yīng)科室就診,告知目前在試管周期內(nèi),選擇合適的藥物及時(shí)治療,復(fù)查時(shí)告知周期醫(yī)生,嚴(yán)禁私自服用藥物及其他治療。如出現(xiàn)嚴(yán)重高熱、外傷、全身性重大疾病等,在相應(yīng)科室就診后需立即告知主治醫(yī)生,明確能否繼續(xù)助孕治療。如出現(xiàn)藥物過(guò)敏或者打針后身體極度不適的情況,應(yīng)及時(shí)告知周期醫(yī)生,必要時(shí)換藥促排。
4、促排針盡可能按時(shí)打,必須每天按醫(yī)囑準(zhǔn)時(shí)注射。
5、促排期間應(yīng)多吃蛋白質(zhì)高的食物如:牛奶、黃豆、魚(yú)、蝦、蛋類(lèi);牛、羊、豬肉。喝的:紅糖姜水(熱喝)、牛奶、黑豆?jié){、蛋白粉等。

三、試管嬰兒移植后的注意事項(xiàng):
1、休息:移植后的48小時(shí),盡量多躺,還要盡量保持平躺。不要在床上大力翻身或大力起床,起身時(shí)先側(cè)身用手支撐身體再起來(lái),48小時(shí)以后就可以斜靠在床上(角度小于45度),少看電視,或不看電視,少上網(wǎng)。可以看一些書(shū)消磨時(shí)間,注意不要是引起情緒激動(dòng)的書(shū)。以后盡量多休息,3天后5天內(nèi)可以在屋內(nèi)少量小幅度活動(dòng),5天后可以從事小幅度的室外活動(dòng),尤其上班不能勞累,較好能夠不上班直至檢測(cè)到已經(jīng)懷孕。平時(shí)保持作息規(guī)律,不要熬夜,睡眠要充分。
2、飲食:多吃蔬菜和富含蛋白的食品。不要吃的東西:酒、煙、咖啡、茶等。
3、心情:保持心情愉快、放松。
4、洗澡:移植后48小時(shí)不洗澡。
5、運(yùn)動(dòng):移植后要避免用力氣的運(yùn)動(dòng),可以慢慢走。
6、保持健康:注意天氣變化,適當(dāng)添減衣服。
| 美國(guó)試管嬰兒 | 泰國(guó)試管嬰兒 |
| 俄羅斯試管嬰兒 | 海外第三方輔助生殖 |
环江|
齐齐哈尔市|
定远县|
蓬安县|
汝城县|
游戏|
理塘县|
泌阳县|
遂昌县|
天津市|
雷州市|
万全县|
洛川县|
淳安县|
铜鼓县|
宁阳县|
济阳县|
白河县|
旬邑县|
卫辉市|
嘉黎县|
武清区|
鹿泉市|
柞水县|
海兴县|
芜湖市|
如东县|
武夷山市|
石门县|
贵阳市|
沧源|
凉城县|
灌云县|
莆田市|
肇东市|
奇台县|
桐梓县|
阳东县|
新平|
海南省|
磐石市|